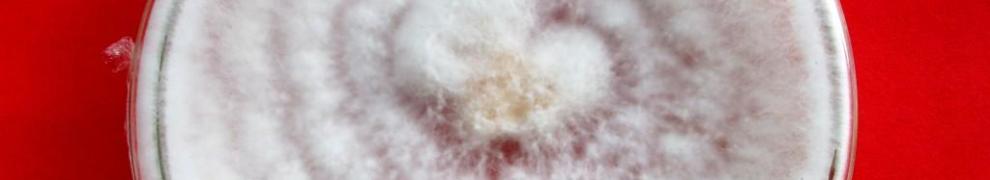

Grafik perubahan komponen lignoselulosa (selulosa, hemiselulosa, HWS, dan lignin setelah diinkubasi dengan jamur pelapuk putih). Perhatikan lignin terdegradasi dengan cepat, sedangkan selulosa relatif konstants
Jamur pelapuk putih memiliki keistimewaan yang unik, yaitu kemampuannya untuk mendegradasi lignin. Jamur pelapuk putih sanggup menguraikan lignin secara sempurna menjadi air (H2O) dan karbondioksida (CO2). Lebih menajubkan lagi, dia lebih suka ‘makan’ lignin daripada selulosa.
Secara garis besar selulosa terdiri dari 3 komponen utama, yaitu lignin, selulosa, dan hemiselulosa. Selulosa berbentuk serat panjang. Rantai selulosa menyatu dengan ikatan hidrogen membentuk serat selulosa. Serat-serat ini diikat menjadi satu oleh hemiselulosa membentuk benang halus. Beberapa serat diikat dan diselubungi oleh lignin.
Hemiselulosa adalah komponen yang paling mudah didegradasi. Selanjutnya, selulosa ‘agak’ mudah terdegradasi. Kebanyakan mikroba suka ‘makan’ selulosa & hemiselulosa ini. Sedangkan lignin adalah komponen yang paling sulit didegradasi, sangat cocok untuk tugasnya sebagai pelindung. Pelindung lignin ini yang membatasi pemanfaatan biomassa lignoselulosa sebagai bahan baku produk2 lain.
Kekuatan lignin ini bisa dicontohkan sebagai berikut. Dalam proses pembuatan kertas, lignin ini harus dihilangkan. Untuk mengurangi & melarutkan lignin ini dipergunakan asam kuat. Misalnya saja H2SO4, bahan air aki. Air aki saja kalau kena baju langsung bolong. Konsentrasi asam yg digunakan sampai 20% dan dilakukan pada suhu >180oC, takanan 2 bar, selama sekitar 2 jam. Luar biasa energi yang diperlukan untuk melarutkan lignin ini. Pantesan saja banyak mikroba yang tidak suka.
Namun, ternyata lignin ini ada musuhnya, yaitu jamur pelapuk putih. Jamur pelapuk putih hobinya makan lignin, makan yang keras-keras. Heran juga saya. Si jamur ini memngeluarkan enzim yang sangat kuat yang disebut enzim ligninolitik. Paling tidak ada empat enzim, yaitu: LiP, MnP, Lac, dan VP.
Sudah lama aku baca diliteratur klo jamur ini lebih memilih makan lignin daripada holoselulosa. Ada juga yang mengatakan kalau jamur ini makan lignin dan sedikit makan holoselulosa. Aku lebih percaya pendapat kedua daripada pendapat pertama. Awalnya seperti itu.
Beberapa hari ini aku sedang mengkoreksi data penelitian temen. Data percobaan degradasi lignoselulosa dengan jamur. Awalnya data itu ditampilkan agak membingungkan. Kemudian aku minta data mentahnya. Aku coba olah sendiri. Hitung sana, hitung sini. Bandingkan antar data. Buat grafiknya. Dan coba analisis statistiknya.
Datanya benar-benar mengejutkan aku. Biomassa lignoselulosa mengalami degradasi. Lignin dan hemiselulosa terdegradasi sangat cepat. Tetapi, selulosanya tidak terdegradasi sama sekali. Massa selulosa relatif tetap sama dari awal sampai akhir percobaan. Aku minta temen dicek ulang data ini untuk lebih meyakinkan lagi. Datanya masih sama. Data ini memperkuat pendapat bahwa jamur pelapuk putih lebih suka makan lignin daripada selulosa.
Hanya saja ada fonomena penurunan kecepatan degradasi lignin dan hemiselulosa. Aku belum tahu kenapa seperti ini.
Data ini masih awal dan saya belum tahu penjelasannya. Perlu analisa pendukung untuk mencari jawabannya.
Namun demikian, hasil ini membuka peluang pemanfaatan jamur yang lebih luas. Dengan bantuan jamur ini selulosa bisa dipanen tanpa perlu melakukan proses yang membutuhkan energi dan biaya tinggi. Setelah selulosa bisa dipanen, mau diolah jadi apa saja bisa.
Jamur mudah ditumbuhkan, mudah diperbanyak, syarat tumbuhnya juga mudah. Ini sangat potensial dilakukan dalam skala sangat besar.
Saat ini penelitian mesti lebih fokus lagi. Pertama, melakukan optimasi dan memepercepat prosesnya. Kalau itu berhasil, target berikutnya adalah melakukannya dalam skala yang besar. Insya Allah.
Artikel saya tentang pemanfaatan jamur pelapuk putih:
BIOLOGICAL PRETREATMENT OF LIGNOCELLULOSES WITH WHITE-ROT FUNGI AND ITS APPLICATIONS: A REVIEW
Posted from WordPress for Android

mantep mas, maju terus ya….
Mas,
Bagaimana mendapatkan bibit JPP itu di alam bebas?
Salam
Slamet
Mesti isolasi dulu dan di cek jamur pelapuk putih atau bukan. Ada banyak sebenarnya di alam bebas. coba lihat posting yang judulnya isolasi jamur makro.
Mas, media spesifik untuk mengisolasi kapang pendegradasi lignin apa ya (tidak hanya JPP tp kapang scr umum)? Saya pernah baca di jurnal sih bisa pake PolyR748, Masalahnya media ini sudah tidak diproduksi lagi, Apa mas tau media alternatif yg laen? Terima kasih sebelumnya
Bisa pakai quaiacol atau tanic acid